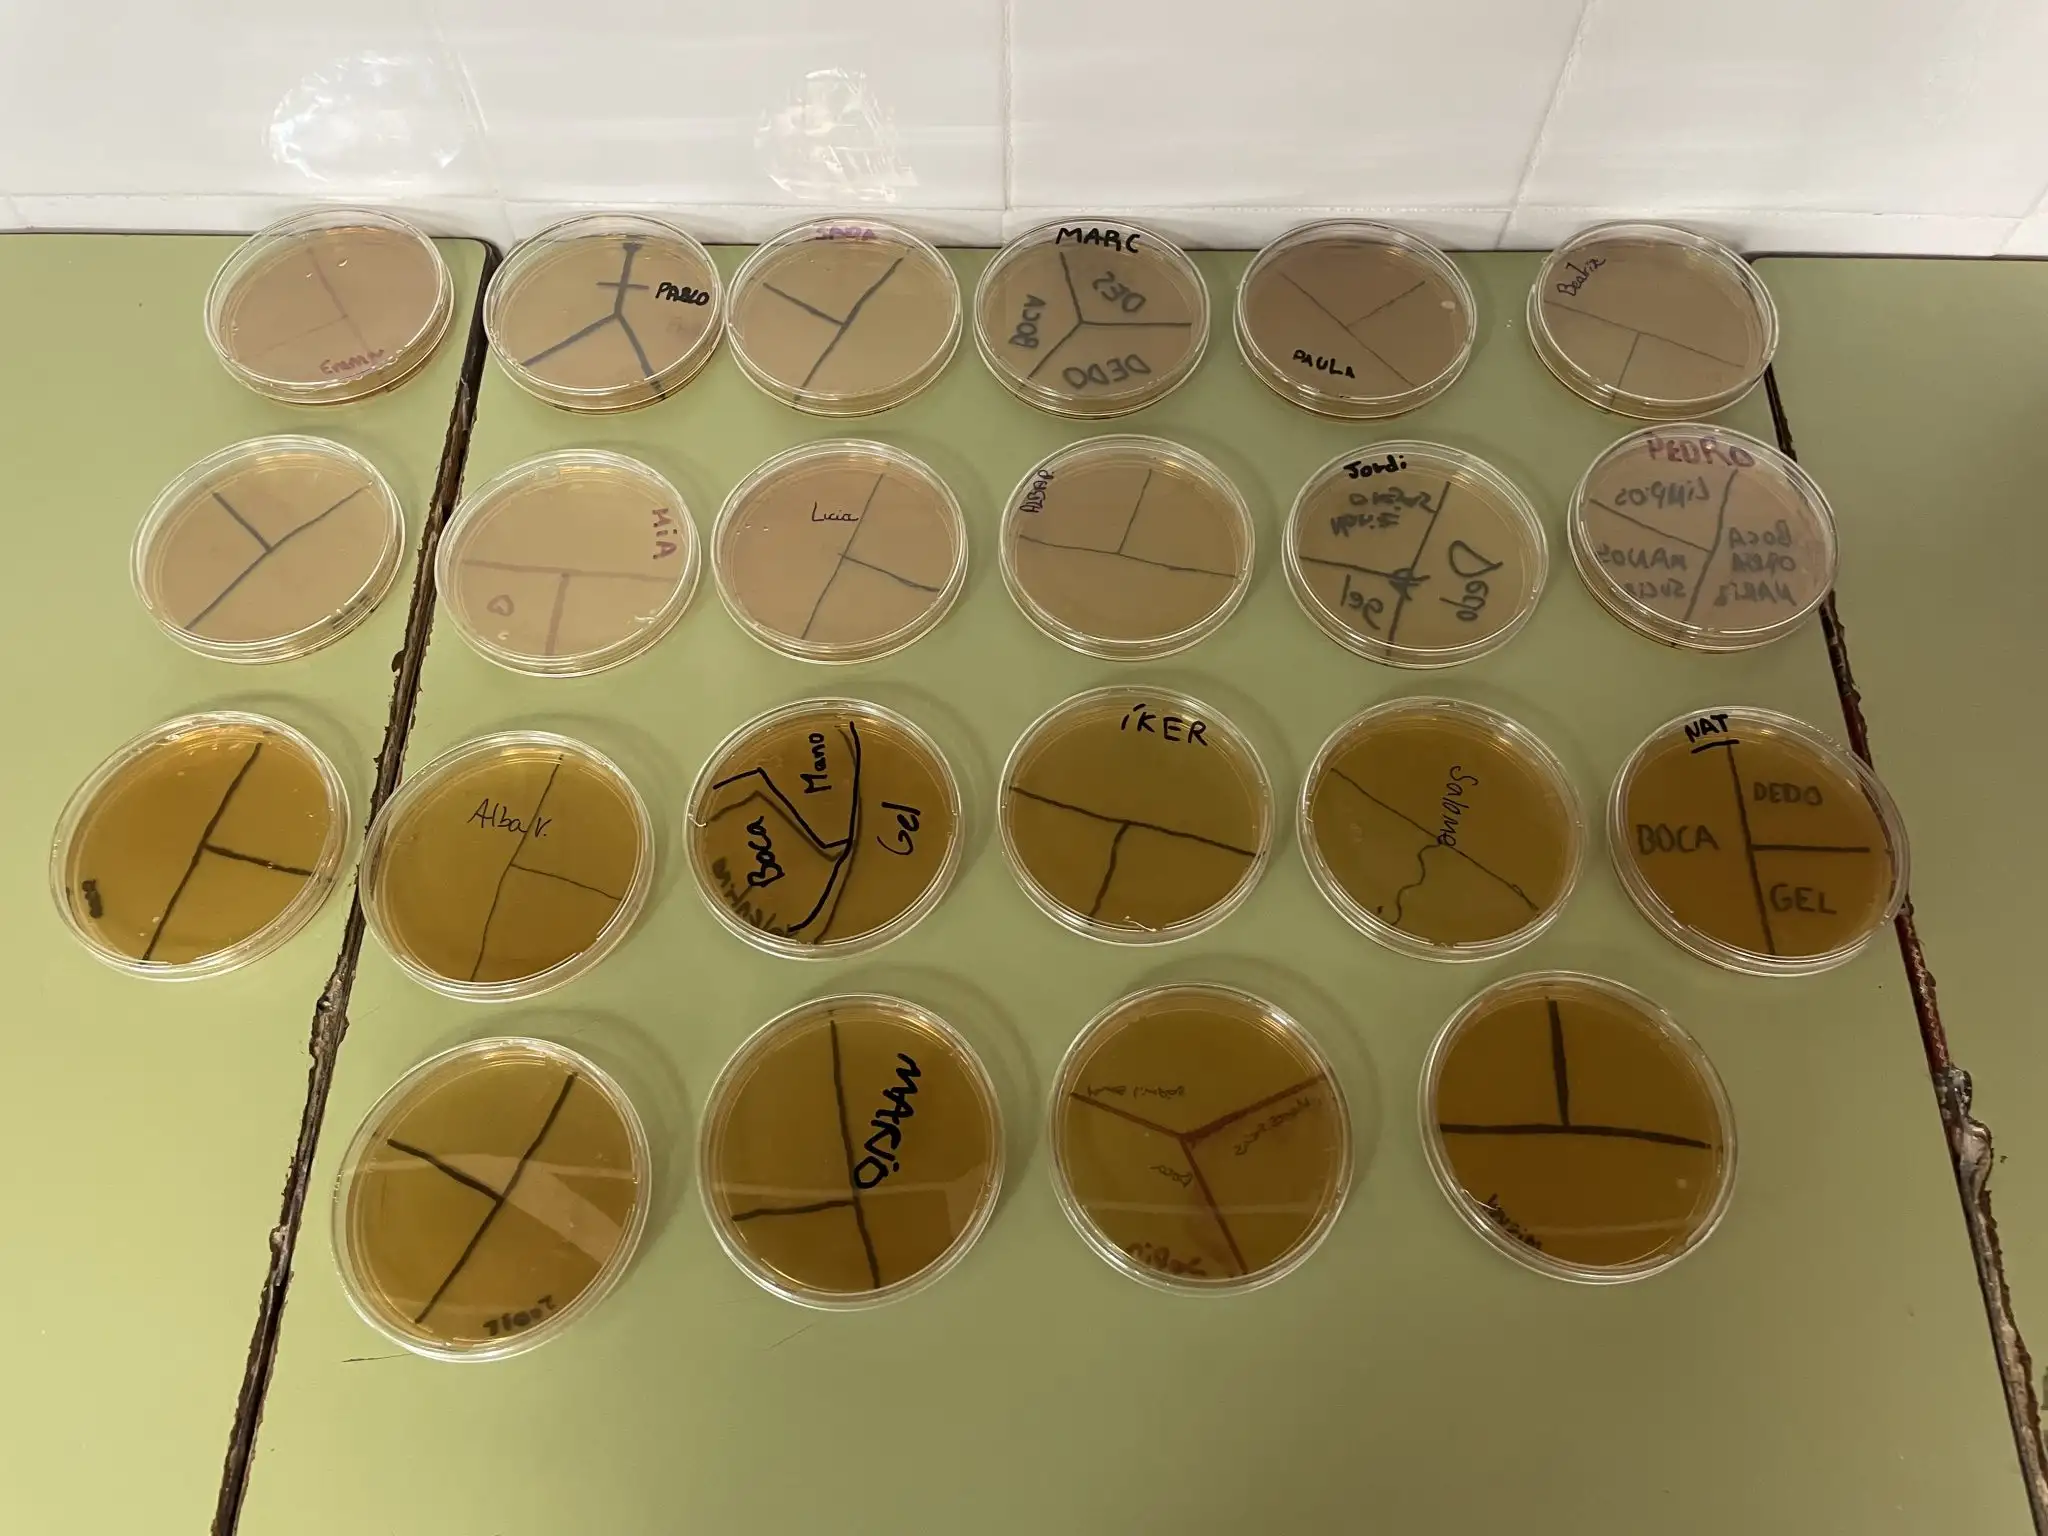

TRIBUNAL DE LES AIGÜES
Dijous 23 d’abril de 2026
L’alumnat de 6é ha presenciat una sessió del Tribunal de les Aigües, on l’objectiu és que l’alumnat conega tot el que envolta aquesta institució mil·lenària. Els permet conéixer en profunditat el funcionament i característiques de la institució i de les sessions dels dijous. Aquesta activitat pretén posar en valor la importància de la institució com a Patrimoni Immaterial de la Humanitat, distinció que la UNESCO va concedir al Tribunal de les Aigües l’any 2009.
*****
El alumnado de 6º ha presenciado una sesión del Tribunal de les Aigües, donde el objetivo es que el alumnado conozca todo el que rodea esta institución milenaria. Les permite conocer en profundidad el funcionamiento y características de la institución y de las sesiones de los jueves. Esta actividad pretende poner en valor la importancia de la institución como Patrimonio Inmaterial de la Humanidad, distinción que la UNESCO concedió al Tribunal de les Aigües en 2009.
CARMEN CALVO
CELEBRACIÓ DIA INTERNACIONAL DE LA DONA
Amb motiu de la celebració del 8 de març, Dia Internacional de la Dona, i en relació amb el nostre projecte de centre “Cultura i Natura, tota una aventura”, la classe de 5é A va triar l’artista valenciana Carmen Calvo per tal de donar visibilitat al paper de les dones valencianes en l’art.
A més de conéixer-la com a artista, aprofundir en la seua tècnica i la seua obra, i plasmar-ho en un mural titulat “CARMEN CALVO: Rescatant objectes, construint igualtat”, l’alumnat també va preparar una sèrie de preguntes dirigides a ella.
*****
CELEBRACIÓN DÍA INTERNACIONAL DE LA MUJER
Con motivo de la celebración del 8 de marzo, Día Internacional de la Mujer, y en relación con nuestro proyecto de centro “Cultura i Natura, tota una aventura”, la clase de 5º A eligió a la artista valenciana Carmen Calvo para dar visibilidad al papel de las mujeres valencianas en el arte.
Además de conocerla como artista, profundizar en su técnica y su obra, y plasmarlo en un mural titulado “CARMEN CALVO: Rescatant objectes, construint igualtat”, el alumnado también preparó una serie de preguntas dirigidas a ella.
SOCARRATS
A la classe d’Arts & Crafts i relacionat amb el projecte de centre “Cultura i natura tota una aventura” l’alumnat de sisé ha tingut l’oportunitat d’endinsar-se en una de les tradicions artesanes més representatives: els socarrats. Per a la seua elaboració, han modelat primer el taulellet amb fang, posteriorment han dissenyat i dibuixat els motius decoratius propis d’aquesta tècnica i, finalment, els han pintat amb molta cura i creativitat. El resultat ha estat un treball artístic molt enriquidor que combina cultura, història i expressió plàstica.
*****
En la clase de Arts & Crafts y relacionado con el proyecto de centro “Cultura y naturaleza toda una aventura” el alumnado de sexto ha tenido la oportunidad de adentrarse en una de las tradiciones artesanas más representativas: los socarrats. Para su elaboración, han modelado primero el azulejo con barro, posteriormente han diseñado y dibujado los motivos decorativos propios de esta técnica y, finalmente, los han pintado con mucho cuidado y creatividad. El resultado ha sido un trabajo artístico muy enriquecedor que combina cultura, historia y expresión plástica.
XELVA, RUTA DE L’AIGUA
Dilluns 30 de març de 2026
L’alumnat de tercer cicle d’Educació Primària del nostre centre va anar fins a Xelva per realitzar la Ruta de l’Aigua, un paratge natural de l’interior de la nostra terra que ens mostra una part de la nostra geografia on l’aigua pren protagonisme i brolla entre les pedres de la muntanya. Ha sigut un viatge i una experiència molt bonica, on hem descobert un entorn natural nou.
*****
El alumnado de tercer ciclo de Educación Primaria de nuestro centro fue hasta Chelva para realizar la Ruta del Agua, un paraje natural del interior de nuestra tierra que nos muestra una parte de nuestra geografía donde el agua toma protagonismo y brota entre las piedras de la montaña. Ha sido un viaje y una experiencia muy bonita, donde hemos descubierto un entorno natural nuevo.
BATUCADA
Dilluns 16 de febrer de 2026
La setmana passada, l’alumnat de sisé va participar en un taller de batucada on van poder aprendre ritmes, coordinar-se en equip i gaudir molt amb la música. Esta activitat els va servir per a preparar-se per al desfile de Carnestoltes del dia següent, que vam celebrar amb molta il·lusió i energia.
*****
La semana pasada, el alumnado de sexto participó en un taller de batucada donde pudieron aprender ritmos, coordinarse en equipo y disfrutar mucho con la música. Esta actividad les sirvió para prepararse para el desfilo de Carnavales del día siguiente, que celebramos con mucha ilusión y energía.
DIA INTERNACIONAL DE LA DONA I LA XIQUETA EN LA CIÈNCIA
Divendres 12 de febrer de 2026
El divendres passat vam gaudir d’una xarrada i taller per a conscienciar sobre el paper de la dona i la xiqueta en la ciència. Ens van visitar dues investigadores de l’Institut d’Agroquímica i Tecnologia d’Aliments de València, que ens van apropar el seu treball i ens van inspirar a continuar despertant en el nostre alumnat vocacions científiques.
*****
El el pasado viernes disfrutamos de una charla y taller para concienciar sobre el papel de la mujer y la niña en la ciencia. Nos visitaron dos investigadoras del Instituto de Agroquímica y Tecnología de Alimentos de València, que nos acercaron su trabajo y nos inspiraron a continuar despertando en nuestro alumnado vocaciones científicas.
VISITA AJUNTAMENT DE VALÈNCIA
Dilluns 9 de febrer de 2026
L’alumnat de 5é de Primària ha visitat l’Ajuntament de València per conéixer de primera mà la història i el funcionament de la nostra administració local. Durant la jornada, han recorregut espais emblemàtics com el Saló de Cristall i el Museu Històric Municipal, on han pogut observar de prop símbols tan rellevants com la Reial Senyera o l’espasa de Jaume I. El moment més destacat ha sigut la pràctica de “Ple Municipal” a l’Hemicicle. Ocupant els escons de l’alcaldia i de les regidories, els xiquets i xiquetes han debatut diferents propostes treballades a l’aula, exercint com a representants de la ciutat per un dia. Una experiència formativa clau per a entendre la democràcia i la nostra identitat.
*****
El alumnado de 5º de Primaria ha visitado el Ayuntamiento de Valencia para conocer de primera mano la historia y el funcionamiento de nuestra administración local. Durante la jornada, han recorrido espacios emblemáticos como el Salón de Cristal y el Museo Histórico Municipal, donde han podido observar de cerca símbolos tan relevantes como la Real Senyera o la espada de Jaume I. El momento más destacado ha sido la práctica de “Pleno Municipal” en el Hemiciclo. Ocupando los escaños de la alcaldía y las concejalías, los niños y niñas han debatido diferentes propuestas trabajadas en el aula, ejerciendo como representantes de la ciudad por un día. Una experiencia formativa clave para entender la democracia y nuestra identidad.






2n PREMI BETLEM ESCOLAR
Dimecres 17 de desembre de 2025
El Betlem del CEIP Mare Nostrum, promogut des de l’assignatura de Religió i realitzat amb l’ajuda de l’alumnat de 6é de primària, ha sigut premiat amb el 2n premi en el Concurs de Betlems que celebra la Delegació d’Ensenyança de l’Aqrquibisbat de València. Al lliurament ha assistit una representació del grup.
*****
El Belén del CEIP Mare Nostrum, promovido desde la asignatura de Religión y realizado con la ayuda del alumnado de 6º de primaria, ha sido premiado con el 2º premio en el Concurso de Belenes que celebra la Delegación de Enseñanza del Arquibisbado de Valencia. A la entrega ha asistido una representación del grupo.